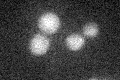
YHR081W
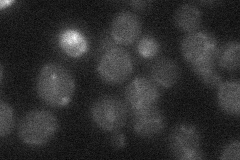
YHR081W
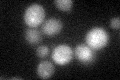
YHR081W

View description
Nuclear exosome-associated nucleic acid binding protein; involved in RNA processing, surveillance, degradation, tethering, and export; homolog of mammalian nuclear matrix protein C1D involved in regulation of DNA repair and recombination
Localization:
Intensity:
Fold change:
Significance:
-
C’ GFP library in SD
below threshold16.16 -
N' NOP1pr-GFP in SD

below threshold12.9854 -
N' TEF2pr-mCherry in SD

missing0 -
N' NATIVEpr-GFP in SD
below threshold18.5808 -
N' TEF2pr-VC and Cyto-VN in SD

below threshold21.2649 -
C’ GFP library in SD+DTT
cytosol15.920.98No -
C’ GFP library in SD+H2O2

cytosol16.391.01No -
C’ GFP library in Starvation Media

cytosol14.240.88No -
C’ GFP library on the background of Pup2-DaMP

below threshold -
C’ GFP library on the background of CCT mutant

below threshold16.58021.02579No
